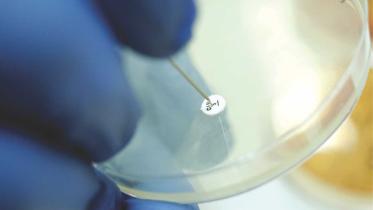
superbug.jpg

Bangladeshi mariner stranded on drone-hit tanker
6 December 2025, 13:54 PM
Special Read
Daria-i-Noor, ‘sister’ to Koh-i-Noor, awaits first light in 117 years
8 October 2025, 15:06 PM
Special Read
Nafisa’s HSC result the last memory left with her mother
16 October 2024, 19:58 PM
Special Read
A glimpse into Zahir Raihan's Films
19 August 2024, 08:55 AM
Special Read
Dubai floods / Thousands of Bangladeshis stranded at Dhaka, Dubai airports
18 April 2024, 13:56 PM
Natural disaster
From outlaws to flower growers
14 April 2024, 06:45 AM
Special Read
'Genuine' SSC, HSC certificates for sale!
1 April 2024, 15:14 PM
Special Read
Counterfeiting currency / Learning from YouTube, he sells them on Facebook
28 March 2024, 14:43 PM
Special Read
Why many countries are trying a four-day work week
21 January 2024, 12:52 PM
Special Read
Shaheed Asad: The spark that lit a fuse in 1969
20 January 2024, 14:11 PM
Special Read
Sorry, a gentle soul
All we did was give him a shelter. But what Sorry probably valued most was the love he got from so many in the Asiatic family and from Joynal, his caretaker.
3 August 2017, 18:00 PM
About Town
Workshop on Stress Management
3 August 2017, 18:00 PM
Not your regular 9-to-5 job
With greater independence in work and better pay, many Bangladeshi workers are turning to freelancing in the online marketplace.
3 August 2017, 18:00 PM
(Un)passing through Jahangirnagar with 'radiant, cool eyes'
56 students were charged with attempted murder and sedition for speaking up against the police brutality that left three students of the 'Protibader Naam Jahangirnagar' road safety movement severely wounded by gunshot and countless others injured.
3 August 2017, 18:00 PM
Man rescued in toy dinghy one mile off English coast
A carefree sailor is rescued from his toy dinghy one mile (1.6km) off the coast of Redcar in north east England after being dragged out to sea by strong currents.
3 August 2017, 06:55 AM
Bollywood superstar Amitabh Bachchan falls asleep while filming
Bollywood superstar Amitabh Bachchan, who is going strong and is busy with several projects, revealed how he actually fell asleep while they were filming a scene in which he had to pretend that he was sleeping, reports NDTV
2 August 2017, 09:36 AM
Drunk woman kisses cop after Kolkata accident
A passionate midnight kiss landed an inebriated woman in Kolkata jail.
31 July 2017, 07:05 AM
Ohio woman calls 911 with boa constrictor ‘stuck to her face’
A woman in Ohio is hospitalised after a boa constrictor reportedly wrapped around her body and latched onto her face.
30 July 2017, 10:54 AM
Chinese woman undergoes plastic surgery to evade $3.7 million debt: media
A 59-year old woman from the central Chinese city of Wuhan transformed her appearance through plastic surgery in order to avoid 25 million yuan ($3.71 million) of personal debts, state news agency Xinhua says.
29 July 2017, 05:10 AM
Translating Donald speak
Translating Donald Trump is, well, an awkward process. After all, the president of the free world has about as much respect for basic grammar, word choice and sentence structure as he does for immigrants, women and the environment.
27 July 2017, 18:00 PM
A light dimmed, a friend buried
Today we break the mould of satire and really talk because it seems we need to.
27 July 2017, 18:00 PM
Humans for sale
Human trafficking in Bangladesh has taken a turn for the worse
27 July 2017, 18:00 PM
Peoples' master plan for a livable future
The National Committee to Protect Oil, Gas, Mineral Resources, Power and Ports is proposing the “Peoples' Master Plan for Power and Energy (2017-2041)” as an alternative to the government's master plan.
27 July 2017, 18:00 PM
Mailbox
The article titled "Finding the superbug" published in Star Weekend on July 7 was shocking!
27 July 2017, 18:00 PM
SNAPSHOT
“Solitude gives birth to the original in us, to beauty unfamiliar and perilous - to poetry. But also, it gives birth to the opposite:
to the perverse, the illicit, the absurd.”
27 July 2017, 18:00 PM
LA man accused of smuggling king cobras in potato chip cans
A Los Angeles man is arrested after federal prosecutors said he arranged to smuggle into the United States three live, highly venomous king cobra snakes hidden in potato chip canisters.
27 July 2017, 05:35 AM
Woman convicted after pet parrot witnesses husband's murder
A woman has been convicted of murdering her husband after the husband’s last words were repeated by the pet parrot who witnessed the attack, reports Independent.
22 July 2017, 07:16 AM
Take a bow, break a leg, and stop the show
Different plays have different curtain calls. One thing is common though—we invariably take the bow in an expression of our humility.
20 July 2017, 18:00 PM
About Town
Alive in the Super Unknown
20 July 2017, 18:00 PM
What about justice for the unheard?
It is a long and difficult struggle for persons with intellectual, hearing and speech disabilities
20 July 2017, 18:00 PM